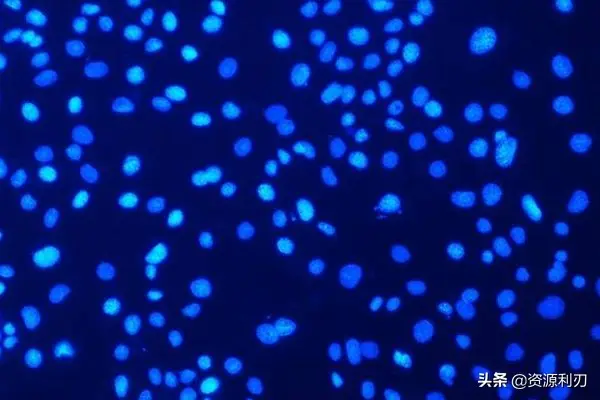
imagej细胞计数步骤（怎么用ImageJ进行自动细胞计数）
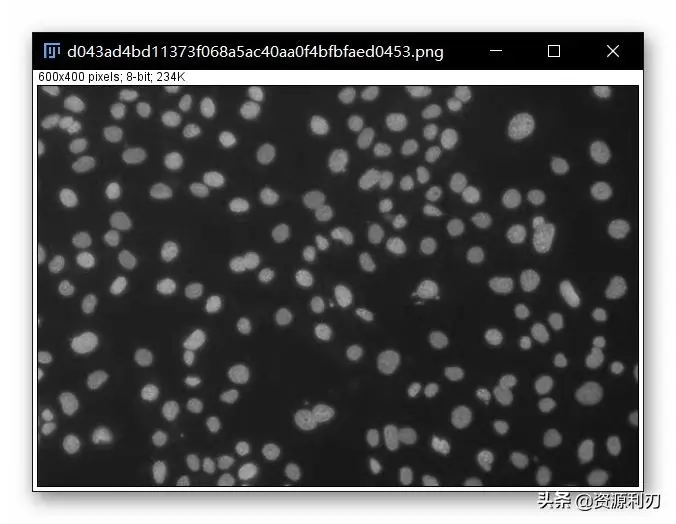
imagej细胞计数步骤（怎么用ImageJ进行自动细胞计数）
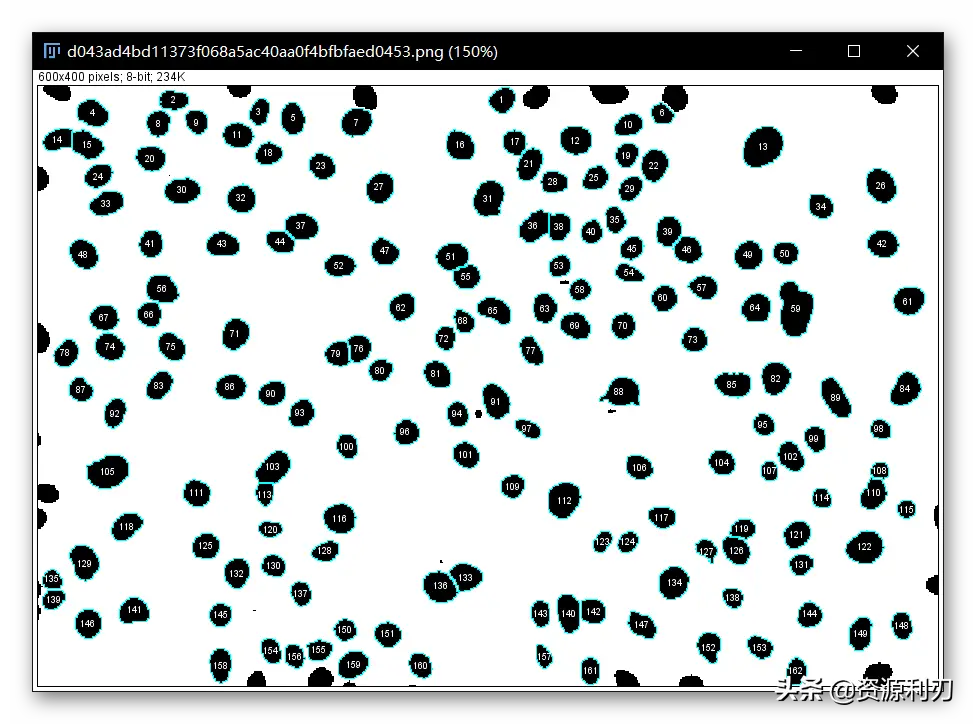
imagej细胞计数步骤（怎么用ImageJ进行自动细胞计数）

imagej细胞计数步骤(怎么用ImageJ进行自动细胞计数)

这里利刃君就为大家带来第一篇ImageJ使用教程,在进行细胞实验时,手动数细胞是一件极其无聊又耗费精力的工作,下面我们就看一下如何利用ImageJ实现自动细胞计数,解放我们的双手。
自动细胞计数
-壹-
导入图像
打开想要处理的图像,这里我们以一张DAPI免疫荧光染色的照片为例进行说明。如下图。

点击File>Open>打开准备好的图像,也可将图片直接拖动到菜单栏,即可打开。如下图。


-贰-
将图像转为8-bit
首先需要将图片转为黑白灰的图像,方便后续识别细胞。
点击Image>Type>8-bit,此时图片即已被去色。

-叁-
调整阈值,去除背景,选中细胞
①点击Image>Adjust>Threshold对阈值进行调整,主要是为了选择细胞区域;


②因为利刃君这里选择的是B&W(Black and White),所以图像中黑色的区域就是已经选中的区域,这里可以进行更改,如若改为red,则红色区域为选中的区域;


③另外我们发现Threshold窗口中有两个调节框,我们可以通过左右拖动调节框中的滑块对选择的区域进行调整。原则是尽可能的包含所有的细胞同时去除背景中的杂质。


④拖动完成后点击Apply,这样阈值就设置好了。
-肆-
填补细胞核的空隙
在调节阈值减少背景的同时,可能细胞的一些不均匀部分也被减弱了,这时就需要进行空隙填补,使得细胞变成实心球形来使自动细胞计数的结果更加可靠。


点击Process>Binary>Fill Holes即可,如果没有出现细胞有空隙的情况,则这一步就不需要进行。
-伍-
打断细胞核的重叠部分
细胞密度比较大时,通常会有细胞重叠或者贴近的情况。就会导致软件识别时将两个粘连在一起的细胞识别为一个,这时我们就需要利用Watershed自动识别重叠部分,随后再将两个细胞分离开来。


点击Process>Binary>Watershed,此时可以看到粘连在一起的细胞已经被分开。


-陆-
自动分析、计数颗粒
点击Analyze>Analyze Particles,出现Analyze Particles界面,根据处理图像的不同,设置不同的参数。
Size:0.05-Infinity——指分析颗粒尺寸大于0.05(一定注意这里的单位是inch),一直到无穷大的颗粒。(根据细胞大小,以及结果好坏来更改)一般可以通过选框工具选择最小的细胞,点击Analyze>Measure来看一下其大小,如我们这里显示Area为104,我们就可以设置Size大小为90-Infinity。


Circularity:0.00-1.00——指圆度,可以根据细胞形状,调整需要的圆度,1.00为标准圆,一般情况下只根据Size进行限制就可以了。
Show:Overlay——指原本图片上会展示出分析结果的外框。
Exclude on edges——处于边缘的颗粒不计入。


设置完成后,点击OK,即出现以下结果,Results窗口中显示了统计出的细胞的数目,并且显示了每个细胞的面积,一共为162个细胞。


另外,我们可以查看原图中有没有漏选或者多选的细胞,如果有可以返回Size设置页面重新设置阈值,再次进行统计。

以上就是利刃君为大家带来的使用ImageJ软件进行自动细胞计数的方法,需要注意的是自动计数的结果并非绝对准确,大家要根据自己的经验优化参数设置,来使结果更加可靠。


相关文章:




